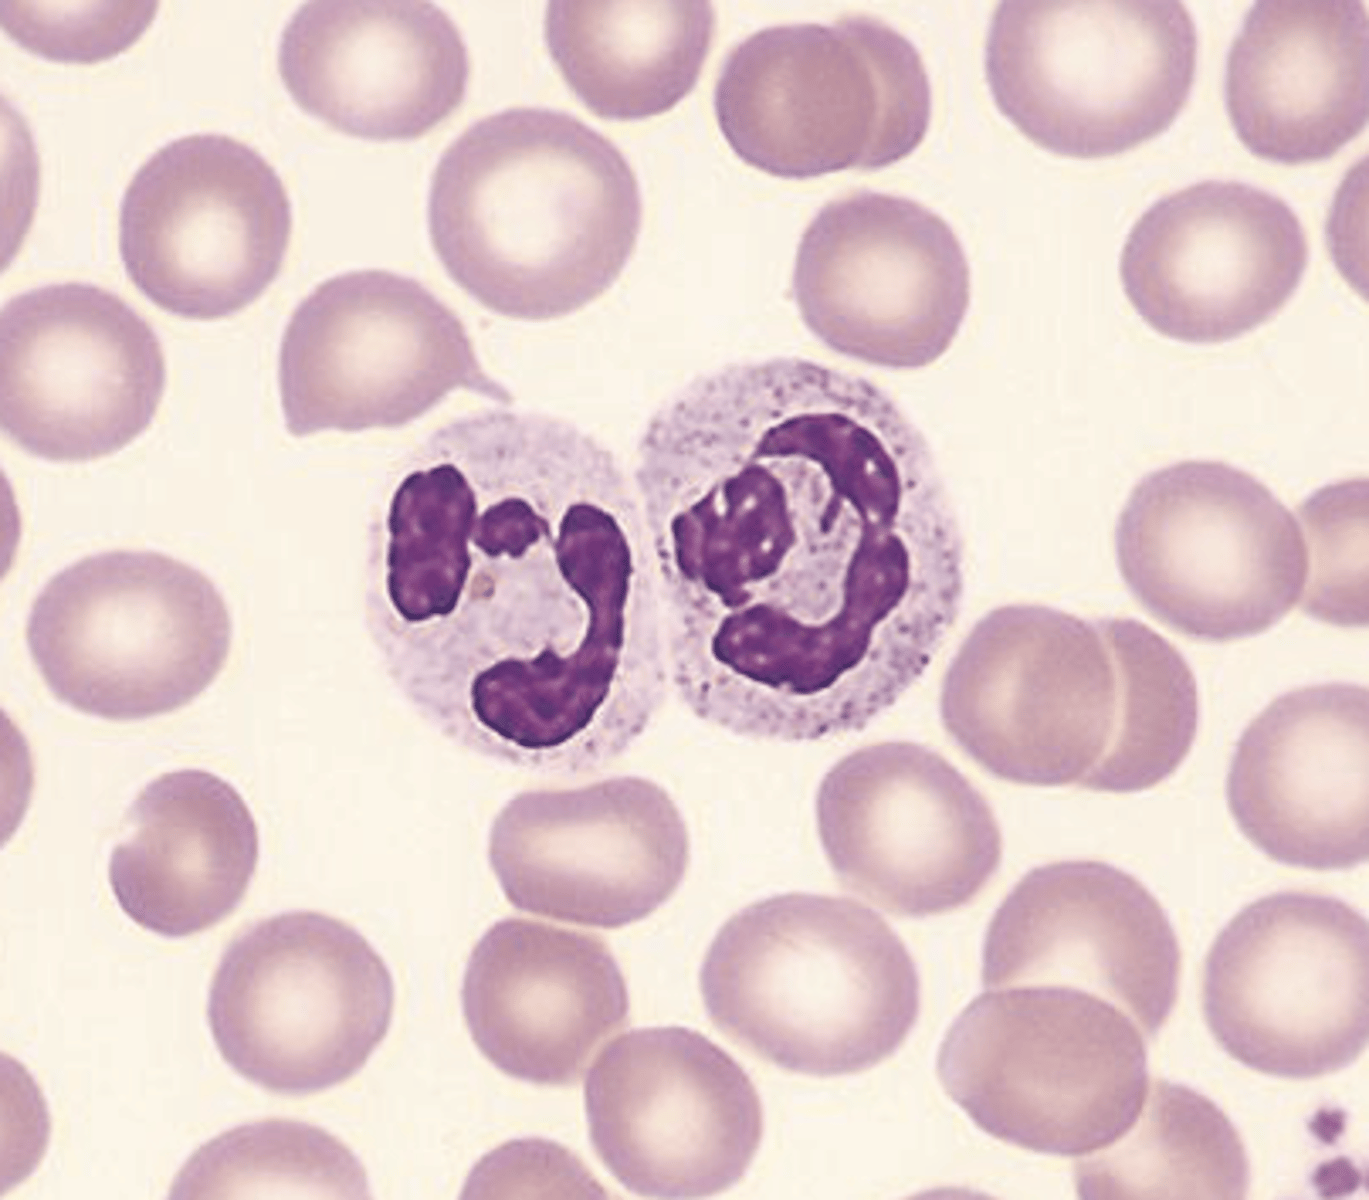
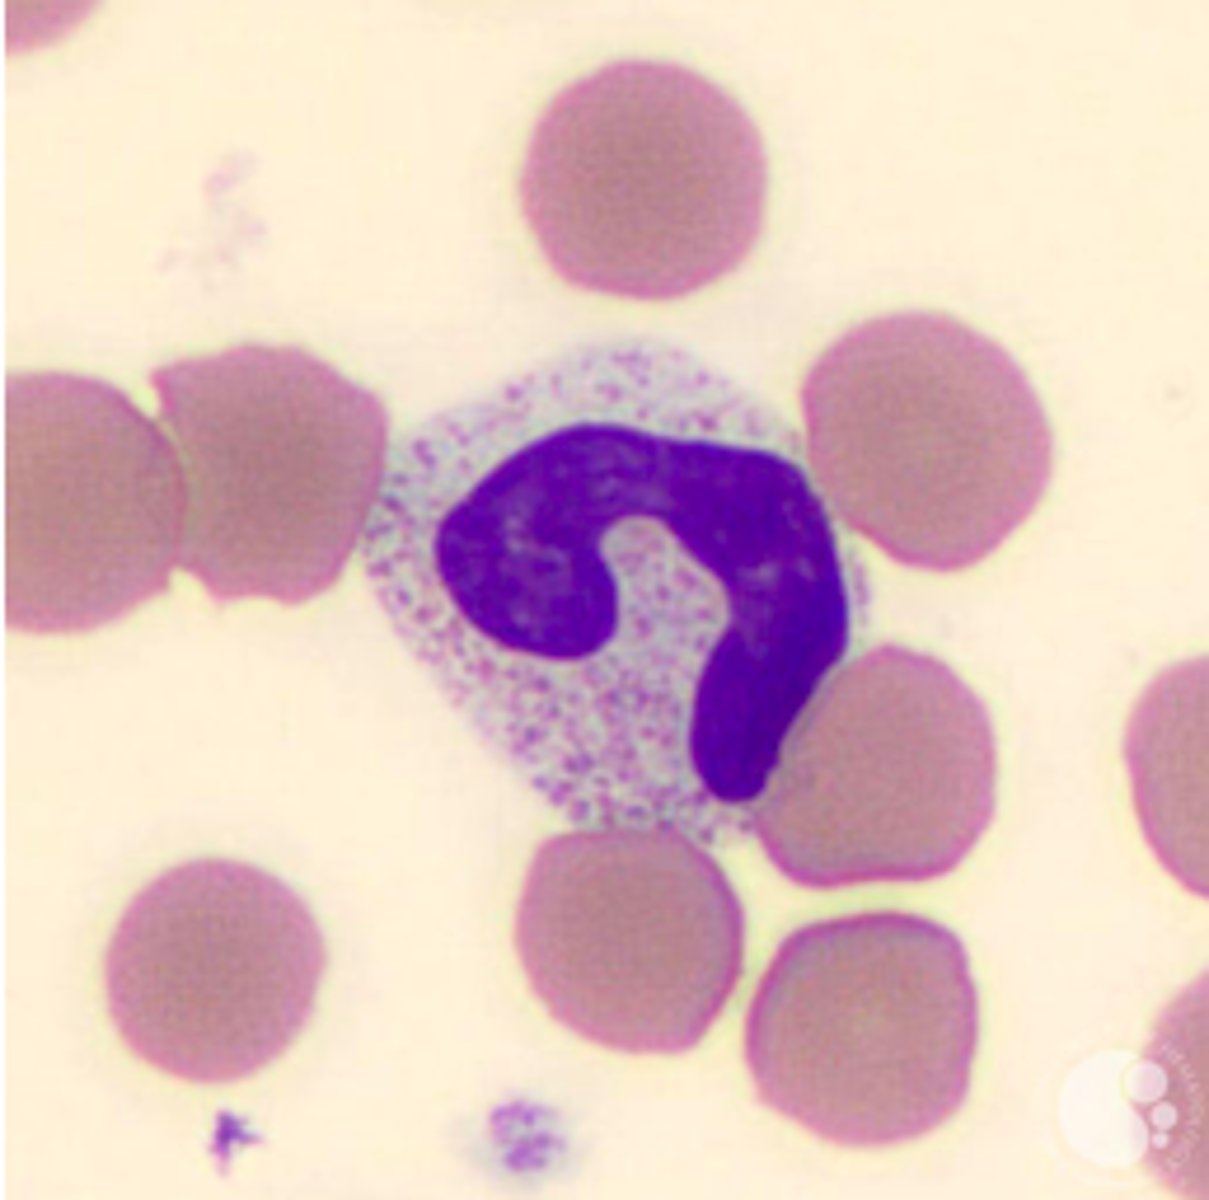
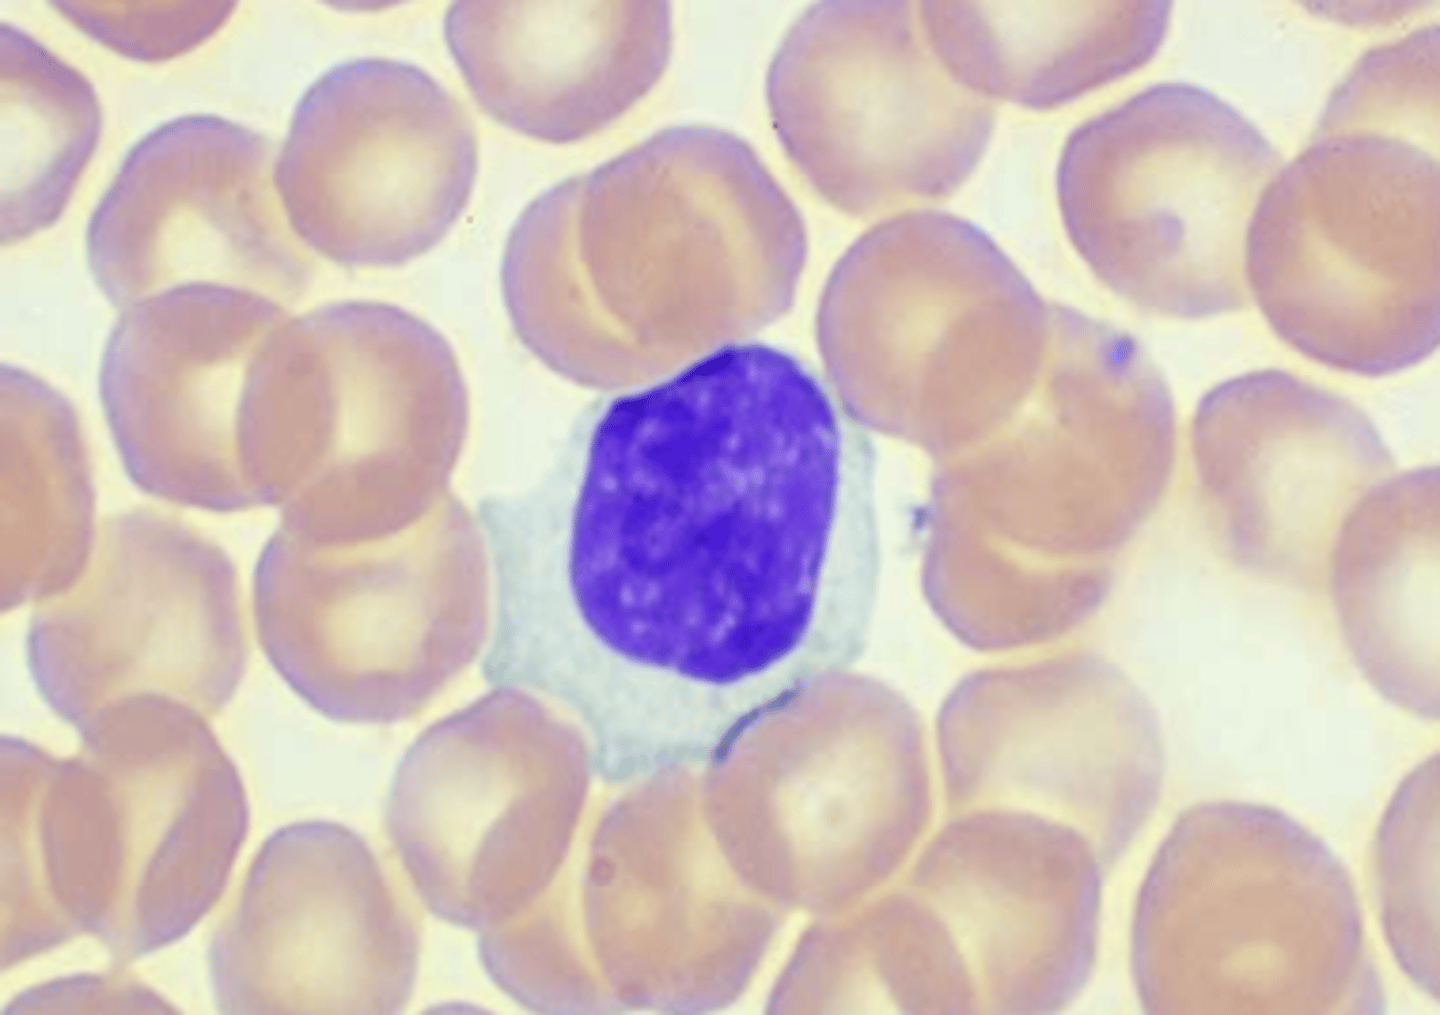
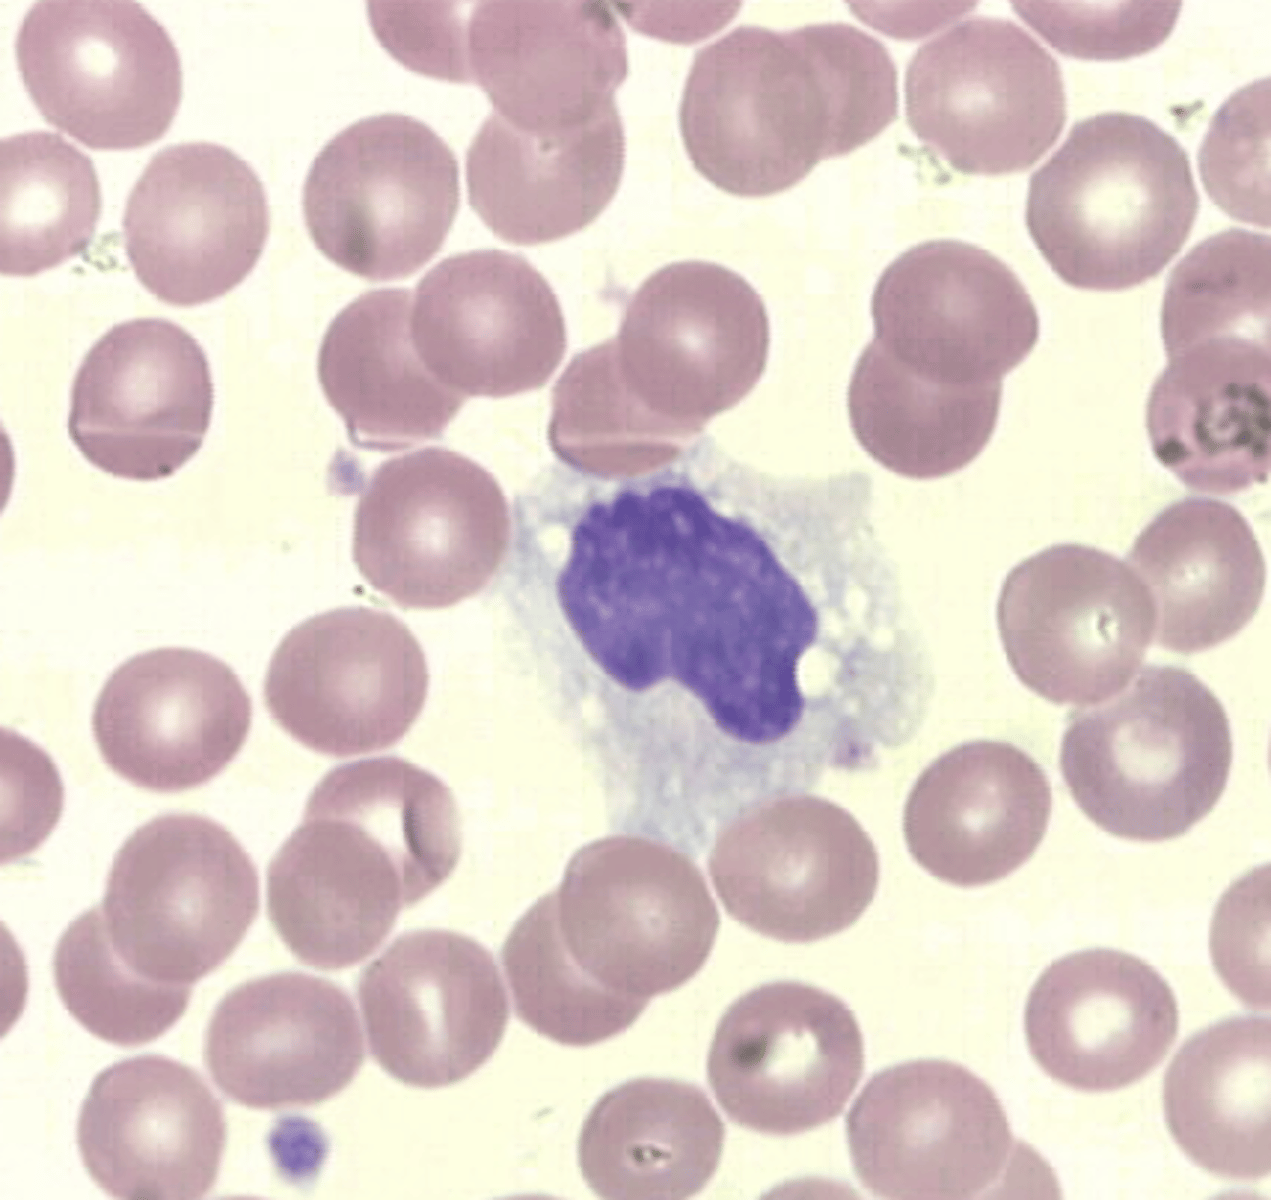
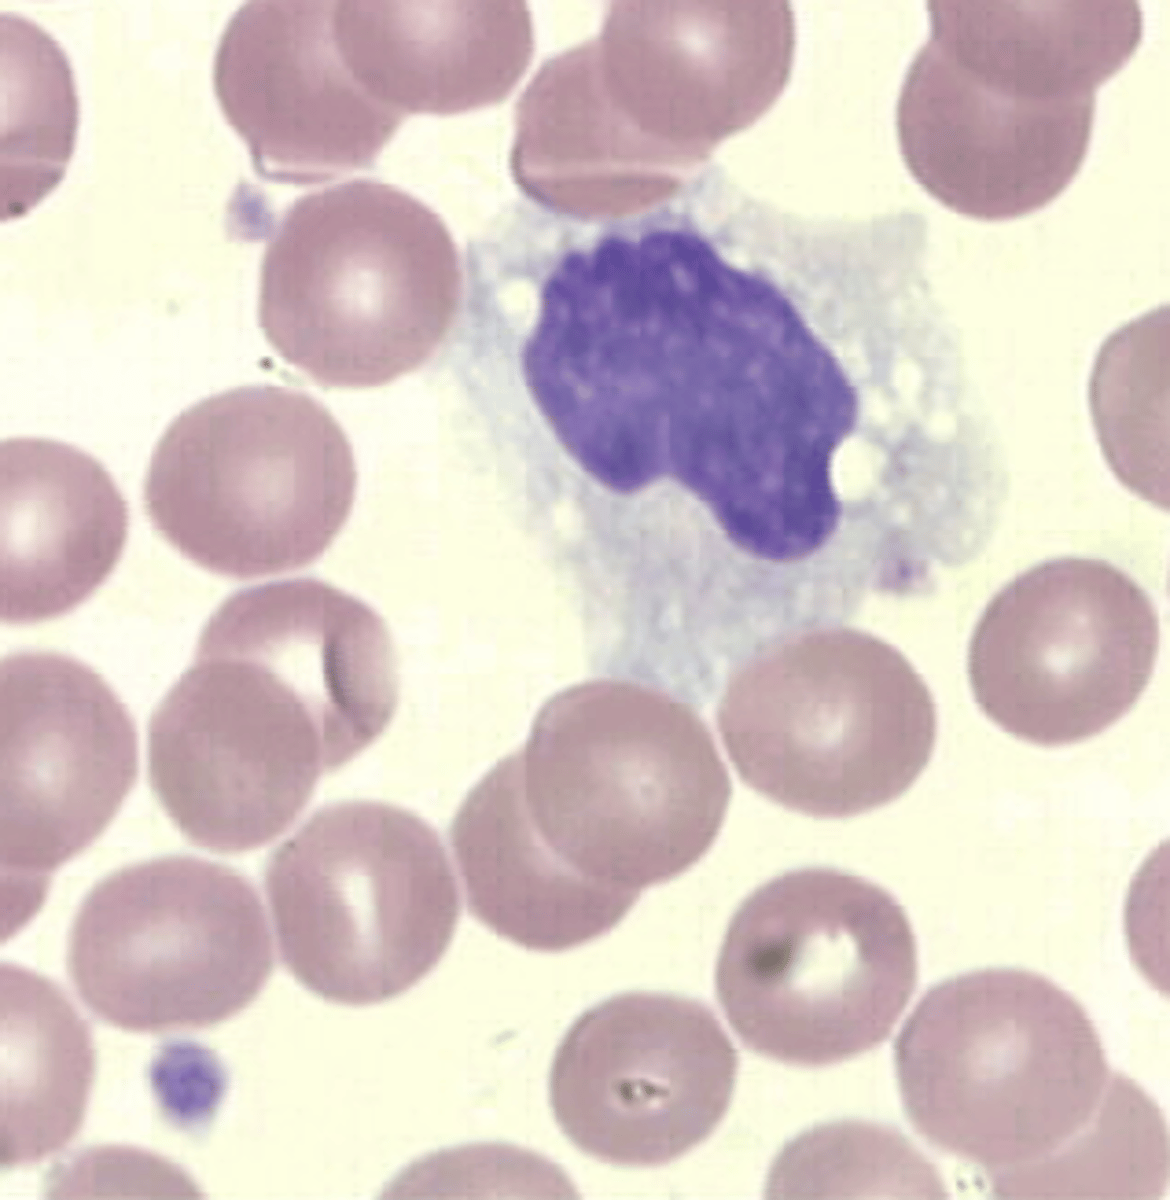

1/37
Looks like no tags are added yet.
Name | Mastery | Learn | Test | Matching | Spaced | Call with Kai |
|---|
No analytics yet
Send a link to your students to track their progress
EDTA means?
EthyleneDiamine Tetra-Acetate (Lavender-Top Tubes)
Hematology is?
It is the study of blood cells.
How many liters of blood does an average human possess?
5 liters of blood.
How does blood transports in the body?
1) It transports oxygen from lungs to tissues.
2) It clears tissues of carbon dioxide.
3) It transports glucose, proteins, and lipids.
4) It moves waste to the liver and kidneys.
What is the role of plasma in the body?
It provides coagulation enzymes that protect vessels from trauma and maintain the circulation.
What are the three categories of blood cells?
1) Erythrocytes - Red Blood Cells (RBCs)
2) Leukocytes - White Blood Cells (WBCs)
3) Thrombocytes - Platelets (PLTs)
What is the Basic Blood Composition?
Average Adult Volume: 4 to 6 liters of Blood
Total Body Weight: 8%
~55% Plasma and ~45% Formed Elements
44% of cells are RBCs
1% of cells are WBCs and Platelets
pH normal range: 7.35 to 7.45
What is the Plasma Composition?
contains 91.5% of water and 8.5% of solutes
What are the three main kind of solutes in plasma?
1) Albumins - 55%
2) Globulins - 38%
3) Fibrinogen - 7%
Red Blood Cells are?
anucleate, biconcave, discoid cells filled with a reddish protein, hemoglobin, which transport oxygen and carbon dioxide.
What is the RBC count used for?
to detect anemia or polycythemia.
anemia -- reduced RBC count
polycythemia -- increased RBC count
What does RBC looks like?
It appears salmon pink and measures 7μm to 8μm in diameter with a zone of pallor that occupies one third of their center, reflecting their biconcavity.

Hemoglobin is?
the protein contained in red blood cells that is responsible for delivery of oxygen to the tissues
Hematocrit is?
the ratio of the volume of packed RBCs to the volume of whole blood.
normal ratio approaches 50%
it is also called packed cell volume.
How do you analyze Hematocrit?
manually determined by transferring blood to a plastic tube with a uniform bore, centrifuging, measuring the column of RBCs, and dividing by the total length of the column of RBCs plus plasma.
What are the RBC Indices?
1) Mean Cell Volume (MCV)
2) Mean Cell Hemoglobin (MCH)
3) Mean Cell Hemoglobin Concentration (MCHC)
4) RBC Distribution Width (RDW)
How does MCV works?
it reflects RBC diameter on a Wright-stained blood film.
it is a volume measurement recorded in femtoliter (fL)
How does MCHC works?
it reflects RBC staining intensity and amount of central pallor.
it is expressed in grams per deciliter (g/dL)
How does MCH works?
it expresses the mass of hemoglobin per cell and parallels the MCHC.
it is expressed in picograms (pg)
How do you calculate the RBC Indices?
it can be calculated manually or by automated profiling instrumentation using formulas with RBC, HgB, and HCT values.
How does RDW work?
it expresses the degree of variation in RBC volume.
Describe a Normal RBC Erythrocyte
> reddish-color Hemoglobin
> no nucleus, unable to synthesize hemoglobin
> produced in response to erythropoietin
> carries oxygen from lungs to tissues
> average diameter: 7μm to 8μm (~size as small Lymphocyte)
> MCV: ~90 fL
> central pallor: 2μm to 3μm (~ 1/3 of cell)
> Anisocytosis: ~5%
Reticulocytes are?
> young RBCs that contain ribonucleic acid (RNA) -- when RNA is visualized using vital stains.

Polychromatic Erythrocytes
Wright-stained Blood Film: 0.5% to 2.5% of RBCs exceed the 7μm to 8μm average and stain slightly blue-gray.
> newly released from RBC production site: the bone marrow -- increased RBC production in anemia.

What is the stain used to differentiate and count Reticulocytes?
Methylene blue dyes called nucleic acid stains or vital stains.
White Blood Cells (Leukocytes) are?
loosely related category of cell types dedicated to protect their host from infection and injury.
What are types of WBCs?
1) Neutrophils
2) Bands
3) Eosinophils
4) Basophils
5) Monocytes
6) Lymphocytes
What are Neutrophils?
> most numerous WBC in adult.
> plays a key role in phagocytosis and inflammation.
> moved by ameboid action.
> migrate from blood vessels to tissues.
> engulf bacteria or fungus.
Segmented Neutrophil (SEGs) are?
> has to to five lobes in the nucleus
> serves as defense against infections.
> cytoplasm stains pink
> granules stain neutral or pink
> secondary granules: lysosomes that contain alkaline phosphatase
Band Neutrophil (BANDs) are?
> horseshoe-shaped nucleus, clumped chromatin
> secondary granules: containing alkaline phosphatase and stains neutral or pink
> occasionally dark primary granules.
> healthy individuals: 2% to 6%
Eosinophils are?
> reddish-orange, large, round, secondary, refractile granules.
> affinity for the acid eosin in Wright's stain
> normal: ~0% to 4% on WBC differential
> diurnal variation: increase at night, decrease in morning
> nucleus is usually bi-lobed

Basophils (Mast Cells) are?
> release histamine in allergic reactions.
> nucleus is segmented, usually bi-lobed.
> large round dark purple-black secondary granules contain histamine and heparin.
> granules have affinity for the blue, basic/alkaline stain in Wright's stain -- may be unevenly distributed
> normal values: 0% to 2% in peripheral blood-acute and delayed allergic reactions.
> diurnal variation as eosinophils.

Lymphocytes are?
> second most numerous type of WBC in the adult, most numerous type in children.
> mature to be either T or B cells depending on whether they migrate to Thymus.
> most are small and round, but size and shape may vary
> nucleus is generally round and very dense
> cytoplasm is blue with deeper intensity at periphery of cell, no granules are present, except in some large lymphs a few azurophilic (red)
> N:C ratio-- 4:1 to 2:1 (nucleus takes up most of cell)

What is the morphology for Small Lymphocyte?
> shape: ~7 to 10 microns
> nucleus: very condenses chromatin ; round, about the size of RBC
> cytoplasm: angular, sky blue ; may only appear as a thin rim around the nucleus

What is the morphology for Large Lymphocyte?
> shape: ~15 microns
> nucleus: larger and more irregular ; chromatin is clumpy
> cytoplasm: much more abundant ; blue rim, colorless near nucleus ; may have "scalloped" edges where it is indented by RBCs
> rarest in PBS
> if it contains adequate granulation, may be part of the "Killer Cells" subpopulation of thymus dependent cells
What is the morphology for Medium Lymphocyte?
> size: 11 to 14 microns in diameter
> N:C ratio -- 2:1 to 3:1
> cytoplasm usually contains azurophilic granules
> non-dividing cells
What is the morphology for Monocytes?
> nucleus: large ; may be kidney shaped, folded, or round ; "brain-like" convolutions, lacy or delicate chromatin
> cytoplasm: dull gray-blue on Wright's stain ; "ground glass" appearance ; may have vacuoles ; may have blunt pseudopod projections
> N:C ratio -- 2:1 or 1:1 (abundant cytoplasm
What is the function of Monocyte?
> leave blood to enter tissues as Macrophage
> are large phagocytic cells
> engulf and digest dead or dying cells and debris
> "garbage collectors"
> account for 2% to 9% for WBC differential